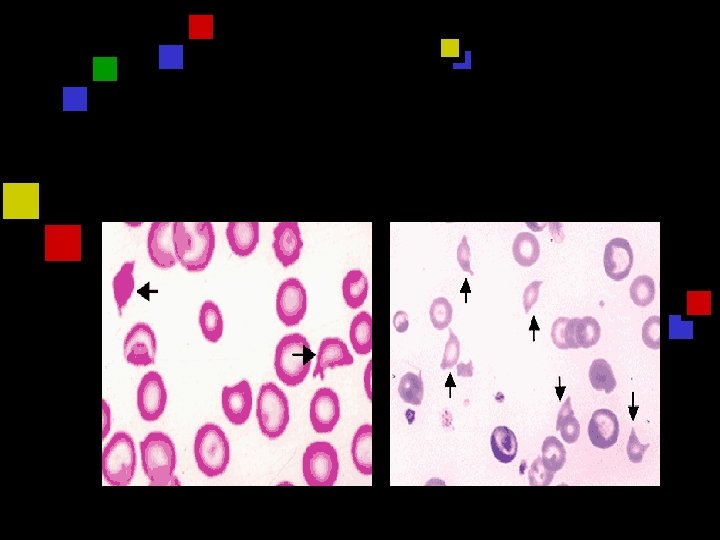

Moschowitz Disease Galila Zaher MRCPath Case Presentation q

- Slides: 42
Moschowitz ‘ Disease Galila Zaher MRCPath
Case Presentation q q q q 20 years old Saudi patient Easy fatigability Easy bruising Afebrile Systemic examination normal Anaemia & thrombocytopenia Blood film High urea & creatinin
Clinical course Abdominal US q Auto-immune profile q Seizures q Plasma pharesis q Normal platelets count q Renal dialysis q Relapse q
Thrombotic Thrombocytopenic Purpura Thrombotic thrombocytopenic purpura (TTP) is characterized by q Microangiopathic hemolytic anemia q Thrombocytopenia q Microvascular thrombosis causes variable degrees of tissue ischemia and infarction q
VWF Biochemistry q q q VWF monomers synthesized in EC Monomers linked into multimers Multimers constructed in megacaryocytes & EC Stored in alpha granules & weibel-palade bodies ULVWF entangled to sub-endothelial collagen Bind to platelets GP 1 b-IX –V and activated plt GPIIb-IIIa adhesion and aggregation Moake et al 1982
VWF Biochemistry q Activation, immobilization and spreading q Recruit more VWF and more platelets q A disintegrin and metalloprotease with eight thrombospondin -1 -like domain ADAMTS q Metalloprotease cleaves ULVWF in A 2 domain q Impaired degradation of VWF by deficiency of metalloprotease Tsai 1996 q Characterization of ADAMTS and elicidation of its c. DNA and gene structure 2001
ADAMTS 13 q Encoded on chromosome 9 q 34 q Produced mainly in liver q Activator : Zn and Ca requiring protein q Inhibitors : metal chelators & EDTA q Substrate : VWF q Plasma activity 50 -178% q Half-life 2 -3 days
Patho-physiology TTP favored by conditions that combine q Increased VWF level (late pregnancy) q Decreased ADAMTS 13 activity q Two-hit model could explain substantial variation in age at which patients with inherited TTP develop symptoms.
Platelet-rich Microvascular Thrombi q Wide spread of intravascular thrombosis q Organ ischemia : Renal, Cerebral q Blood flows through turbulent area of partially occluded by platelet aggergates q Schistocytes q High LDH correlates with severity of ischemia
Clinical Presentation Pentad q Thrombocytopenia (increased marrow megakaryocytes) q Microangiopathic hemolytic anemia (MAHA) q Renal failure (50%) q Neurologic abnormality (25%) q Fever q Thrombocytopenia , schistocytes & elevated LDH q Nonspecific symptoms: weakness, abdominal pain, nausea, vomiting, and diarrhea q Median duration of symptoms prior to diagnosis was 6 days Oklahoma TTP-HUS Registry
Types Of TTP q Congenital TTP q Acquired idiopathic TTP q Secondary TTP
Congenital Familial TTP q q q Moschowitz ‘ Disease Rare : Autosomal recessive Homozygous mutations in both ADAMTS 13 alleles q Both parents showing 50% of activity q Infancy or childhood q Severe ischemic brain lesions by MRI q ADAMTS 13 < 5% of normal plasma q Almost always have ULVWF multimers q Response to FFP infusion is rapid : Prophylactic FFP q 2 -3 weeks avoid relapses
Conditions Associated q Bone marrow transplantation q Pregnancy & Postpartum q Drugs q Autoimmune disorders q TBI q Kidney, liver, heart, or lung transplant
Drug-associated TTP q Acute immune-mediated or dose-related toxic q Most common cause of immune-mediated TTP q Quinine ( isolated thrombocytopenia) q Ticlopidine (TTP and HUS) q Clopidogrel (TTP and HUS) q Mitomycin C- Cyclosporine q Tacrolimus (FK 506) q Discontinuation or dose adjustment is sufficient q Trial of plasma exchange : efficacy is uncertain
Acquired idiopathic Adults and older children q Sever ADAMTS 13 deficiency : acute episodes q Ig. G autoantibody produced transiently q Return to normal upon recovery q Mortality rate 13% q Worse prognosis : Prolonged courses & more frequent complications q
HUS q Children, usually >5 years old q Bloody diarrhea q E. coli O 157: H 7 q Shiga toxin q Acute renal failure q Thrombocytopenia and MAHA q Mortality is 3 -5% q Normal plasma ADAMTS 13 activity q Plasma exchange treatment is rarely considered
Laboratory Tests q q q q Anemia Thrombocytopenia Blood film : (Schistocytes > 1% of total RBCs) High LDH (hemolysis and leakage from ischemic tissue) High bilirubin DCT negative High urea and ceriatnin PT , APTT, fibrinogen & D-dimers : normal
Diagnosis No “gold standard” for diagnosis q ADAMTS 13 activity q Auto-antibodies against ADAMTS 13 q
Clinical Applications Diagnosis q Discrimination of TTP from HUS q Discrimination of congenital and acquired q Estimating risk of relapse q Monitoring therapeutic efficacy of plasma exchange or plasma infusion. q
Furlan q q q q q NP VWF as substrate Test plasma is activated by barium chloride Mix over night in presence of 1. 5 M urea Separated by SDS agarose gel electophoresis Followed by immunoblotting. Excellent resolution leader Very sensitive Reproducible Requires several days
Bohm et al Test plasma is incubated with recombinant substrate q Separated by SDS polyacrelamide gel q Quantitate residual VWF using RIPA q Short incubation q
Immunoassay Assay Residual VWF binding to collagen after its degradation q ELISA simple q Fast few hours q Less sensitive and less precise q Problems with reproducibility q
Low Levels Of ADAMTS PLiver disease q DIC q Chronic metabolic conditions & inflammatory conditions q Uremia q HIT q Pregnancy third trimesters q Newborn q Healthy controls : levels 20 -50% and none < 10% q
Management q Untreated almost always fatal (90%) q FFP Byrnes and Khurana 1977 q Cryo-supernatant contain ADAMTS Tsai 1998 q Solvent/detergent-treated plasma contain ADAMTS Tsai and Lian and Furlan 1998
Plasma pheresis q q q q Plasma exchange reduced MR from 90%- 25% Remove circulating ULVWF multimer-platelet strings Remove circulating auto-antibodies against ADAMTS 13 Infusion of FFP or cryosupernatant , SD or methylene blue/light-treated plasma Response rate 80%– 90% T 1/2 of infused ADAMTS 13 activity is 2 days Prompt and complete response : no furtherapy
Risk For Relapse q Severe ADAMTS 13 deficiency q Idiopathic TTP auto-Abs q Non following SCT q No relapse following drug toxicity q No relapse who had a prodrome of bloody diarrhea Oklahoma TTP-HUS Registry
Management Of Relapse q Most relapses occur within the first year q Suboptimal response or relapse : steroids q Sever neurologic defect : immunosuppressive treatment q Spleenectomy: eliminates autoantibodyproducing B cells
Acquired idiopathic TTP Lower titers better responses q High titer inhibitor wore prognosis q Inconsistent response to steroids and other immunosuppressive agents q Rituximab or cyclophosphamide q Removal of autoantibody-producing cells by splenectomy. q
Pregnancy And TTP During pregnancy , postpartum 70% around time of delivery q Pre-eclampsia/HELLP : 3 rd trimester or following delivery, HT , protinurea & Spontaneous postpartum recovery q Observation for several days after delivery q Acute, severe multi-organ failure : prompt plasma exchange q
TTP Following BMT q Post allogeneic : 2 -76% q Post autologous : 0 -27% q Mortality rate : 0 -93% q DD : Renal and neurotoxicities of GVHD q Cyclosporine and Tacrolimus q Clinically suspected TTP: efforts to diagnose & treat GVHD and sepsis & delay a decision for plasma exchange q ADAMTS 13 activity : normal q No response to plasma exchange
HIV q Typical TTP q Acquired autoantibody to ADAMTS 13 q Rapidly fatal course q Plasma exchange : one plasma volume once daily q Glucocorticoids auto-antibodies to ADAMTS 13
n. Thank you
Central Venous Catheter Insertion q Deaths q Cardiac arrest with near-death q Hemorrhage q Pneumothrax q Pericardial tamponade q Allergic reactions q Severe hypotension and hypoxia q Fatal sepsis
ADAMTS 13 Absent Clinical Presentation ADAMTS 13 mutations Familial TTP; chronic relapsing TTP i. Presentation in infancy/childhood ii. Disease presentation delayed Autoantibodies against ADAMTS 13 i. Transient ii. Recurrent iii. Thienopyridine-associated Acquired idiopathic TTP Single episode Recurrent (intermittent) TTP Ticlopidine/clopidogrel-TTP ADAMTS 13 transient production or survival (? ) defect Acquired idiopathic TTP (? ) Pregnancy-associated TTP
q q q q Tsai Plasma samples incubated with guanidine HCl-treated VWF X 1 hr Products separated by SDS–polyacrylamide gel electrophoresis Immunoblotting Obert et al Plasma samples incubated with recombinant VWF overnight Degraded VWF fragments detected by two-site immunoradiometric assay Performed in hospital laboratory High-throughput method Gerritsen et al Functional assay Preferential binding of HMWt forms of VWF to collagen. Plasma treated with EDTA to abolishes the VWF-cleaving activity. Dialyzed against the buffer and used as substrate.
q q q Recombinant protein as ADAMTS 13 substrate E coli culture Direct assay for measuring ADAMTS 13 product generation More accurate Protease-free VWF. Substrate tagged with two different molecules makes it easy to modify the detection of product. One potential disadvantage : GST-VWF 73 -H is not a natural substrate
Sensitivity And Specificity q Specificity: Severe deficiency (<5% ) is specific q. Sensitivity remains questionable 66%- 100% Tsai and Lian. q. Levy et al identified 12 gene mutations
Parameter Finding Neurologic findings None 0 Confusion, lethargy, behavioral changes 1 Focal neurologic deficits, convulsions, stupor, coma 2 None 0 BUN > 30 and < 70 mg/d. L and/or creatinine ? 1. 5 mg/d. L and < 2. 5 mg/d. L, and/or proteinuria > 2 g per day and/or hematuria 1 BUN >= 70 mg/d. L and/or creatinine >= 2. 5 mg/d. L and/or dialysis 2 > 100, 000 per L 0 20, 000 – 100, 000 per L 1 < 20, 000 per L 2 > 12 g/d. L 0 9 -12 g/d. L 1 < 9 g/d. L 2 Renal function impairment Platelet count at presentation Hemoglobin level at presentation Points
Differential Diagnosis • Thrombotic thrombocytopenic purpura (TTP) • Immune thrombocytopenia purpura (ITP) • Autoimmune hemolytic anemia • Hemolytic uremic syndrome (HUS) • Pregnancy, eclampsia • Disseminated intravascular coagulation (DIC) • Septicemia with DIC • Systemic lupus erythematosus (SLE) • Scleroderma • Paroxysmal nocturnal hemoglobinuria (PNH)
Comparison of the features of TTP and hemolytic uremic syndrome (HUS) Feature TTP HUS Age Peak incidence at 40 years Childhood Gender Female Equal Epidemic No Yes Re-occurrence Common Rare Link to E. coli 0157: H 7 Occasional Yes Renal failure Uncommon Common Neurologic Common Uncommon Thrombocytopenia Severe Moderate to severe Organ involvement Multiple Limited to kidney